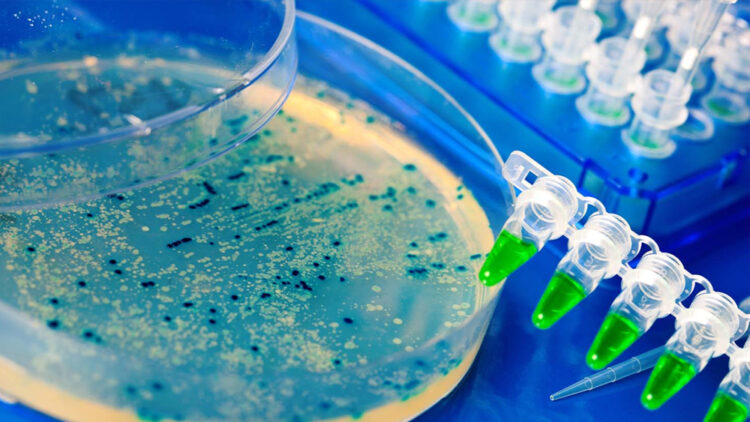

കൊറോണ മഹാമാരി ലോകത്തെ പിടിച്ചുകുലുക്കിയ ഈ സാഹചര്യത്തിൽ ഇനിയും ഒരു വൈറസ് എന്ന് കേൾക്കുമ്പോൾ തന്നെ എല്ലാവരും ആശങ്കപ്പെട്ടേക്കാം. മഹാമാരി ജനങ്ങളുടെ മനസ്സിൽ വരുത്തിയ ആഘാതം അത്രമാത്രം വലുതാണ്. എന്നാൽ ഒന്നല്ല അയ്യായിരം വൈറസുകളെയാണ് ഗവേഷകർ ഇപ്പോൾ കണ്ടെത്തിയിരിക്കുന്നത് എന്നാണ് റിപ്പോർട്ട്. സമുദ്രത്തിൽ വ്യാപകമായി ഈ വൈറസുകൾ വിഹരിക്കുന്നുണ്ടെന്നാണ് പഠനം.
ലോകത്തിന്റെ വിവിധ ഭാഗങ്ങളിലായി നിരവധി അപകടകാരികളായ വൈറസുകളെ കണ്ടെത്തിയിട്ടുണ്ടെങ്കിലും അതിൽ മിക്കതും മനുഷ്യനെ ബാധിക്കാറില്ല. എന്നാൽ ഇപ്പോൾ കണ്ടെത്തിയ വൈറസുകൾ മനുഷ്യരെ വ്യാപകമായി ബാധിക്കുമെന്നാണ് പഠനങ്ങൾ തെളിയിക്കുന്നത്. മനുഷ്യരെ ബാധിക്കുന്ന അസുഖങ്ങൾക്ക് കാരണമാവുന്ന ആർഎൻഎ വൈറസുകളുടെ വിഭാഗത്തിൽ പെടുന്നവയാണ് ഇവ. ജലദോഷം മുതൽ കൊറോണ വരെയുള്ള രോഗങ്ങൾക്ക് കാരണാമാവുന്നവയാണ് ആർഎൻഎ വൈറസുകൾ. മനുഷ്യരെ കൂടാതെ മൃഗങ്ങളെയും ചെടികളെയും ഇത് ബാധിക്കുന്നു. ഈ വൈറസുകൾ തമ്മിൽ വേർതിരിച്ചറിയാൻ സാധിക്കില്ല എന്നതാണ് മറ്റൊരു പ്രശ്നം.
സമുദ്രത്തിൽ കണ്ടെത്തിയ ആർഎൻഎ വൈറസുകൾ കേന്ദ്രീകരിച്ചിരിക്കുന്നത് ചെറിയജീവികളായ പ്ലാങ്ക്തണുകളിലാണ്. സമുദ്രജീവികളുടെ ഭക്ഷ്യ ശൃഖലയുടെ ആദ്യ കണ്ണിയായി കണക്കാക്കുന്ന പ്ലാങ്ക്തണുകൾക്ക് വെള്ളത്തിൽ പൊങ്ങിക്കിടക്കാൻ ശേഷിയുണ്ട്. ഈ പ്ലാങ്ക്തണുകളുടെ കൂട്ടത്തിലാണ് വൈറസുകളെ കണ്ടെത്തിയിരിക്കുന്നത്.
ഗവേഷകർ നടത്തിയ പരീക്ഷണത്തിൽ 5504 വൈറസുകളെ കണ്ടെത്തിയിട്ടുണ്ട്. ആർട്ടിഫിഷ്യൽ ഇന്റലിജൻസിന്റെ സഹായത്തോടെ ആർഎൻഎ ഘടകം മസ്സിലാക്കി ഇവയുടെ സാമ്യവും അന്തരവും തിരിച്ചറിഞ്ഞ് വൈറസുകളുടെ എണ്ണം തിട്ടപ്പെടുത്തി. ലോകത്തെ എല്ലാ സമുദ്രങ്ങളിലും ഈ വൈറസുകളുടെ സാന്നിദ്ധ്യം ഉണ്ടെന്നാണ് ഗവേഷകർ പറയുന്നത്. പടിഞ്ഞാറൻ പസിഫിക്കിലും, അൻറാർട്ടിക് മേഖലകളിലും മാത്രമാണ് ഇവയുടെ കുറവ് കണ്ടെത്തിയിരിക്കുന്നത്.
ഭൂമിയിൽ ജീവൻ ഉത്ഭവിച്ച സമയത്ത് തന്നെ വൈറസ് ബാക്ടീരിയ പോലുള്ള സൂക്ഷ്മജീവികളുടെ സാന്നിദ്ധ്യവും ഇവിടെയുണ്ട്. സ്വയം നിലനിൽക്കുന്നതിനോടൊപ്പം മറ്റ് ജീവജാലങ്ങളുടെ ശരീരത്തിൽ പ്രവേശിച്ച് അവയെ നിലനിർത്തുകയോ തകർക്കുകയോ ചെയ്യുന്നു. ഇത് ജീവന്റെ നിർണായക ഘടകമായതിനാലാണ് വൈറസുകളെക്കുറിച്ച് പഠിക്കാൻ ഗവേഷകർ തീരുമാനിച്ചത്. ഈ വൈറസുകൾ മനുഷ്യന് വെല്ലുവിളിയാകുമോയെന്നും ഗവേഷകർ പഠനം നടത്തുന്നുണ്ട്.

Comments